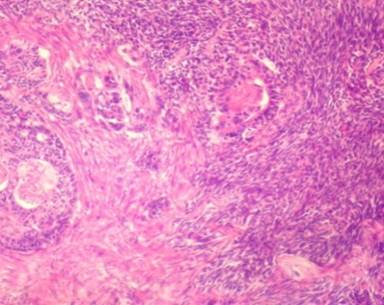

CASE REPORT
JOP. J Pancreas (Online) 2015 May 20; 16(3):310-312.
Carcinosarcoma of the Pancreas: How a Common Blood Disorder Can Hide an Extremely Rare Tumour
Anastasios Katsourakis1, Christos Svoronos1, Efthimios Chatzitheoklitos1, Iosif Hadjis1, Michael Alatsakis1, Charalambos Mirelis1, Apostolos Sovatzidis1, George Noussios2
1Department of Surgery, Agios Dimitrios General Hospital; 2Laboratory of Anatomy of Department of Physical Education (at Serres), Aristotle University of Thessaloniki. Thessaloniki, Greece
ABSTRACT
Context Sarcomas represent a relatively rare malignancy. Primary sarcomas of the pancreas represent an extremely rare pathology. Case report We report a case of primary pancreatic carcinoma that presented with anaemia. The patient underwent a Kausch-Whipple operation, and, 16 months after the operation, the patient is disease free. Conclusion This unique case describes an extremely rare gastrointestinal tumour that was found during the patient's anaemia assessment.
INTRODUCTION
Primary sarcomas of the pancreas represent an extremely rare pathology that accounts for less than 0.1% of pancreatic malignancies and only 11cases have been described in the English literature. The histogenesis of carcinosarcomas is not clearly understood. It is an aggressive tumour associated with a poor prognosis. The treatment of choice is surgical resection followed by adjuvant chemotherapy based on gemcitabine and cisplatin.
CASE REPORT
Α seventy-year-old man was admitted to our department for an elective left inguinal hernia repair. During the preoperative assessment, the patient was found with low haematocrit.
The patient had been on simvastatin the last five years, the rest of his medical history was negative. There was no relevant family or social history. In his physical examination, the patient was pale with no evidence of jaundice. The patient lost 10 kg during the past year without dieting and was suffering from symptoms of depression during the same period. An abdominal examination revealed an indirect left inguinal hernia. A rectal examination was normal. Investigations confirmed low haemoglobin 8.3 g/dL and haematocrit 25%.The rest of the biochemical examinations were normal. In the tumour markers, only the CA (carbohydrate antigen) 19-9 was elevated with a value of 169.67 U/mL. An abdominal ultrasound and colonoscopy showed non-pathological results. The gastroscopy revealed a large tumour of the ampulla of Vater (Figure 1), while the histology was positive for malignant cells with sarcomatous characters and frequent mitotic figures (>40/10 high power fields). The computed tomography scan demonstrated a large mass of the ampulla of Vater, causing obstruction and dilatation of the common bile duct, the intrahepatic and the pancreatic duct (Figure 2). The magnetic resonance revealed a large mass of the uncinate process of the pancreas of 4.7x4.5 cm and the dilatation of the intrahepatic bile ducts, common bile duct and pancreatic duct with no invasion of the superior mesenteric vessels or the portal vein and no metastasis.

|
Figure 1. Gastro-duodenoscopy demonstrating a tumor at the ampulla of Vater. |

|
Figure 2. CT of the abdomen which shows a mass at the ampulla of Vater with dilated common bile duct, pancreatic duct and intrahepatic ducts. |
The patient underwent a Kausch-Whipple operation. Upon gross examination, the head of the pancreas revealed an exophytically-growing tumour localised in the duodenum orally to the ampulla of Vater that measured 11x9x6 cm. The resection margins and lymph nodes were tumour free, from the 14 that were resected.
Microscopically, the tumour yielded two components. The first component was a relatively well-differentiated adenocarcinoma, while the second component showed poorly-differentiated solid tissue of mesenchymal origin (Figure 3). Immunohistochemically, the epithelial component was strongly reactive for antibodies to CK7 and CD34, while the sarcomatoid component was negative for all CK antibodies but strongly reactive for the antibody to vimentin (Figure 4). The postoperative period was uneventful. The patient was discharged the ninth postoperative day. A venous port implanted six weeks after the operation and he received eight cycles of gemcitabine. Despite the poor prognosis, the patient is still alive and without evidence of the disease 16 months after the operation.
|
Figure 3. Histological examination revealed duct-like and spindle-shaped atypical cells (left) and carcinosarcoma appearance (right) after hematoxylin and eosin stain (magnification x45). |

|
Figure 4.Immunohistochemical staining of the epithelial component showing positivity to CK 7 (cytokeratin) (magnification x 45). |
DISCUSSION
Carcinosarcomas are biphasic neoplasms consisting of two components: the malignant epithelial and the mesenchymal, both demonstrating distinct immunohistochemical and molecular features pertaining to their different lines of differentiation [1, 2]. The histogenesis of carcinosarcomas is not clearly understood. Four main hypotheses have been proposed: the collision, the combination, the conversion and the composition theories [3, 4]. ‘Conversion’ indicates that a section of the carcinoma transforms into a sarcomatous element, ‘combination’ describes the development of a tumor from a single stem cell that differentiates into epithelial and mesenchymal tissues ‘collision’ refers to the invasion of carcinomatous and sarcomatous elements into each other, and finally the 'composition' theory when the sarcomatous component is an exuberant, non-neoplastic overgrowth of connective tissue in reaction to the presence of neoplastic carcinoma.
Regarding the pancreas, only a few cases of carcinosarcoma have been reported in the literature (Table 1) [5-14]. According to Feather et al. [15], sarcomas of the pancreas occur frequently in younger patients with the pancreatic head being most commonly involved, followed by the tail and the body of the organ. Because of its extreme rarity, the histogenesis of pancreatic carcinosarcoma remains unclear. The identification of identical DNA sequences in multiple genes supports the hypothesis that carcinosarcomas derive from a single stem cell. Several studies have suggested a monoclonal origin for carcinosarcomas using diverse immunohistochemical and molecular analyses [2].
Table 1. Review of the literature of patients with carcinosarcoma of the pancreas.
|
Author |
Age |
Histology of non-epithelial component |
Mucinous cystic component |
Survival (months) |
|
Millis et al. |
50 |
Leiomyosarcoma |
No |
3 |
|
Watanabe et al. |
76 |
Osteoclastic giant cells |
No |
3 |
|
Wenig et al. |
48 |
Spindle shaped stroma |
Yes |
12 |
|
Wenig et al. |
65 |
Spindle shaped stroma |
Yes |
9 |
|
Wenig et al. |
67 |
Spindle shaped stroma |
Yes |
15 |
|
Darvishian et al. |
74 |
Malignant fibrous histiocytoma |
No |
- |
|
Yamazaki et al. |
90 |
Spindle shaped stroma |
No |
- |
|
Barkatullah et al. |
67 |
Spindle shaped stroma |
No |
8 |
|
Bloomston et al. |
67 |
Spindle shaped stroma |
Yes |
4 |
|
Gelos et al. |
61 |
Spindle shaped stroma |
Yes |
9 |
|
Ambe et al. |
52 |
- |
- |
- |
|
Our case |
70 |
Spindle shaped stroma |
Yes |
16 |
An immunohistochemical diagnosis is established by the reactivity of the carcinomatous and sarcomatous elements to CK and vimentin, respectively. Carcinosarcomas must be differentiated from sarcomatoid carcinomas, which immunohistochemically are positive only to CK [16].
Carcinosarcoma of the pancreas is an aggressive tumour that carries a poor prognosis. The treatment of choice is surgical resection followed by gemcitabine as an adjuvant treatment [17]; a combination with cisplatin has been associated with a high resection rate and improved survival in the neoadjuvant setting in a preliminary study [18].
Received January 07th, 2015 – Accepted March 28th, 2015
Keywords Anemia; Carcinosarcoma; Pancreas
Conflicting Interest The authors had no conflicts of interest
Correspondence Anastasios
Katsourakis
Department of Surgery, Agios Dimitrios General Hospital
Thessaloniki
Greece
Phone: + 23-13.322.129
Fax: + 23-13.322.131
E-mail: tasoskatsourakis@hotmail.com
References
1. Baylor SM, Berg JW. Cross classification and survival characteristics of 5000 cases of cancer of the pancreas. J Surg Oncol 1973; 5:335-358. [PMID: 4355621]
2. Hyun-Soo K, Sun Hyung J, Dal Mo Y. Carcinosarcoma of the Pancreas: A Unique Case with Emphasis on Metaplastic Transformation and the Presence of Undifferentiated Pleomorphic High-Grade Sarcoma. J Gastrointestin Liver Dis 2011; 20:197-200. [PMID: 21725518]
3. Abeln EC, Smit VT, Wessels JW, et al. Molecular genetic evidence for the conversion hypothesis of the origin of malignant mixed mullerian tumours. J Pathol 1997; 183: 424-431. [PMID: 9028738]
4. Wada H, Enomoto T, Fujita M. Molecular evidence that most but not all carcinosarcomas of the uterus are combination tumors. Cancer Res 1997; 57:5379-5385. [PMID: 9393763]
5. Bloomston M, Chanona-Vilchis J,Ellison EC, et al. Carcinosarcoma of the pancreas arising in a mucinous cystic neoplasm. Am Surg 2006; 72:351-355. [PMID: 16676863]
6. Darvishian F, Sullivan J, Teichberg S, et al. Carcinosarcoma of the pancreas: A case report and review of the literature. Arch Pathol Lab Med 2002; 126:1114-1117. [PMID: 12204065]
7. Gelos M, Behringer D, Philippou S, et al. Pancreatic carcinosarcoma. Case report of multimodal therapy and review of the literature. JOP. J Pancreas (Online) 2008; 9:50-55. [PMID: 18182744]
8. Nakano T, Sonobe H, Usui T. Immunohistochemistry and k-ras sequence of pancreatic carcinosarcoma. Pathol Int 2008; 58:672-677. [PMID: 18801090]
9. Watanabe M, Miura H. Mixed osteoclastic/pleomorphic-type giant cell tumor of the pancreas with ductal adenocarcinoma: Histochemical and immunohistochemical study with review of the literature. Pancreas 1997; 15:201-208. [PMID: 9260206]
10. Ambe P, Kautz C, Shadouh S, et al. Primary sarcoma of the pancreas, a rare histopathological entity. A case report with review of literature. WJSO 2011; 9:85 [PMID: 21812970]
11.Yamazaki K. A unique pancreatic ductal adenocarcinoma with carcinosarcomatous histology, immunohistochemical distribution of hcG-beta, and the elevation of serum alpha-feto-protein. J Submicrosc Cytol Pathol 2003; 35:343-349. [PMID: 15137676]
12. Millis JM, Chang B, Zinner MJ and Barsky SH Malignant mixed tumor (carcinosarcoma) of the pancreas: a case report supporting organ-induced differentiation of malignancy. Surgery 1994; 115:132-137. [PMID: 82844754]
13. Wenig BM, Albores-Saavedra J, Buetow PC, Heffess CS. Pancreatic mucinous cystic neoplasm with sarcomatous stroma: a report of three cases. Am J Surg Pathol 1997; 21:70-80. [PMID: 8990143]
14. Barkatullah SA, Deziel DJ, Jakate SM, KluskensL, Komanduri S. Pancreatic carcinosarcoma with unique triphasic histological pattern. Pancreas 2005; 31:291-2. [PMID: 16163064]
15. Feather HE, Kuhn CL. Total pancreatectomy for sarcoma of the pancreas. Ann Surg 1951; 134:904-912. [PMID: 14885957]
16. Huszar M, Herczeg E, Lieberman Y, et al. Distinctive immunofluorescent labeling of epithelial and mesenchymal elements of carcinosarcoma with antibodies specific for different intermediate filaments. Hum Pathol 1984; 15:532-8. [PMID: 6373564]
17. Oettle H, Post S, Neuhaus P, et al. Adjuvant chemotherapy with gemcitabine vs observation in patients undergoing curative-intent resection of pancreatic cancer: a randomized controlled trial. JAMA 2007; 297:267-7. [PMID: 17227978]
18. Palmer DH, Stocken DD, Hewitt H, et al. A randomized phase 2 trial of neoadjuvant chemotherapy in resectable pancreatic cancer: gemcitabine alone versus gemcitabine combined with cisplatin. Ann Surg Oncol 2007; 14:2088-96. [PMID: 17453298]